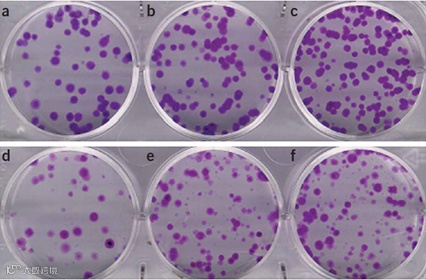

克隆生成实验(Clonogenic assay)是一种细胞生物学技术,用于研究特定处理方式对细胞存活和增殖的影响。克隆生成实验通常用于癌症研究,以确定药物或射线对肿瘤细胞增殖的作用以及或者用于滴定病毒溶液中细胞杀伤颗粒(CKPs)的数量。
克隆生成实验涉及三个主要步骤:
处理细胞样品(加入药物\病毒\或者辐照处理)。
将细胞“铺板”在组织培养孔板上使其生长。
将产生的细胞固定,染色并计数。
实验结束时,测量存活下来的细胞百分比。存活率相对于药物浓度或电离辐射剂量的图形表示称为细胞存活曲线。

图1 克隆生成实验的主要步骤,处理细胞样品,细胞铺板和染色计数。
详细步骤:
1. 使用胰蛋白酶消化并收获细胞。收获细胞之前用PBS洗涤细胞,除去PBS,并用含胰蛋白酶的无血清细胞培养基代替,对细胞进行消化。
2. 胰蛋白酶消化细胞,制备单细胞悬液。胰蛋白酶溶液应留在细胞上,直至观察到聚集现象为止;这可以在显微镜下检查。
3. 当细胞开始聚集时表明已脱离培养皿,将细胞重悬于含血清培养基中,抑制胰蛋白酶消化。补充足量的含血清的培养基(胰蛋白酶体积的3-4倍)以中和胰蛋白酶溶液。通过上下吹吸移细胞悬液来分离细胞。
4. *计数细胞(关键步骤)。需要精确的接种细胞数量才能获得正确的对照组和实验组,以求得正确存活率的正确接种效率(PE)数据。
5. *将细胞悬浮液稀释至所需的接种浓度(关键步骤),然后根据需要接种6孔板中。关键步骤,必须准确进行稀释以接种正确数量的细胞。
克隆增殖实验设计
这里有2种方法:方法一适合药物处理,方法二适合辐照处理。
方法一:药物处理前将细胞铺板。从原种培养物中收获细胞,并以适当的稀释度接种到六孔板种。在将细胞附着到培养皿上后,通常需要2个小时或更长时间,然后对细胞进行处理。处理必须在细胞开始复制之前进行;否则,每个培养皿的细胞数将增加,产生更多的克隆。处理后,将培养皿放置在培养箱中,并在此放置数个细胞分裂的时间。此方法通常用于快速筛选细胞对不同药物处理的敏感性。
(A)处理前进行铺板(i)细胞培养板的每个孔收获指数生长期的细胞,并重新接种适当数量的细胞(这取决于处理的严重程度;如果您不知道合适的效果,请使用不同细胞数的不同稀释度)。留出时间让细胞附着到培养皿塑料表面。通常,这需要在37℃下花费几个小时。用显微镜检查细胞的附着情况。(ii)在实验中根据需要处理培养皿或孔中的细胞,然后至少将培养皿一式两份放置在培养箱中。培养箱必须适应细胞生长要求。永远不要忘记湿度:在培养箱的底部放置一个装有清水的托盘,以防止培养过程中培养皿中的培养基变干。将培养皿留在培养箱中,直到对照培养皿中的细胞已形成足够大的克隆(通常要求克隆包含超过50个细胞(这是要计数的最小值),默认大于50个细胞的克隆是活细胞克隆)。
方法二:将细胞放在培养皿中处理后,再以合适的稀释度重新铺板,以评估克隆形成能力。细胞铺板可以在处理后立即进行,也可以延迟后再进行。此方法特别用于放射生物学研究中,以确定潜在的致死和亚致死性损伤修复。
(B)处理后进行细胞铺板。使用细胞计数仪对所得细胞悬液中的细胞数进行计数。为了研究电离辐射后潜在的致命伤害修复程度,辐照处理后立即铺板或延迟铺板。如果不能在处理后细胞铺板,则最好将细胞放在冰上,再进行铺板。延迟铺板的延迟时间通常在6至24小时之间。6小时后,大部分致命的损坏修复已完成。如果不知道损伤的严重程度,推荐使用不同的细胞稀释度进行预实验。实验至少一式两份。(ii)将培养皿放在培养箱中,直到培养皿中的细胞形成足够大的克隆为止。

常规的克隆生成实验中,通常接种100-200细胞,需要生长3-4周,再进行固定;使用Azure Sapphire多光谱激光成像系统,可以接种400-500细胞,只需要生长1.5-2周(10-14天)就可完成,因为 Azure Sapphire多光谱激光成像系统成像分辨率为10μm,可以更清晰的分辨细胞克隆的检测限(50个细胞克隆尺寸约为50.8μm2),同时能够输出数字文件,使用软件进行计数。使用Azure Sapphire多光谱激光成像系统能够节省一半的时间,由于接种细胞更多,获得的数据方差更小,实验组和对照组比较,更容易获得显著差异。
克隆的固定和染色
6. 去除细胞上方的培养基。
7. 用PBS仔细冲洗。
8. 去除PBS,并加入2-3 ml 6.0%戊二醛和0.5%结晶紫的混合溶液(或使用考马斯亮蓝)。
9. 染色至少30分钟。
10. 小心除去戊二醛结晶紫混合物,并用自来水冲洗。请勿将培养皿放在正在出水的水龙头下,而要在水槽中注满水并小心地将培养皿浸入水中。
11. 将带有克隆的培养皿放在室温干燥。
12. 染色后内进行计数。
克隆计数
13. A方法:标准程序是使用体式显微镜进行计数。在图1中,给出了SW-1573人肺肿瘤细胞克隆形成检测结果的典型示例
图2 在六孔板上进行克隆增殖实验的传统方法,检测SW-1573肺癌细胞产生的克隆。(a,b)接种100和200个细胞后形成的未经处理的对照分别具有70和115个克隆。(c)接种400个细胞后,这里有太多克隆重叠,因此c孔对于计数是不可靠的。(d,e)4Gy辐射处理后,分别接种400和800个细胞后,形成39和66个克隆。(f)接种1600个细胞后,这里有太多克隆重叠,因此计数不可靠。4Gy辐照后,许多细胞仍分裂2至3倍,并形成了少于50个细胞的小菌落,但无法存活。
14. B方法:使用Sapphire多光谱激光成像系统,将400-500个细胞/孔接种在6孔板上,并用药物处理10天。未经处理的细胞用作对照。随后将细胞进行染色。使用Sapphire多光谱激光成像658nm激光扫描,获得数据结果,测量细胞克隆集落的数量和大小。通过ImageJ分析评估菌落形成效率。菌落定义为由至少50个细胞组成(面积为40-50μm2)。未经处理的对照设为100%。

图3. 使用Sapphire多光谱激光成像系统进行克隆增殖实验,扫描6孔板获得的图像结果。

图4. 使用Sapphire多光谱激光成像系统进行克隆增殖实验,扫描6孔板获得的图像结果放大后的局部结果。
15. PE是细胞克隆数量与接种细胞数的比值(接种后再处理)。

多次实验要取平均值,PE = (PE1 + PE2+ PE3)/3
16. 细胞处理后再接种,得到的PE数值,称为存活分数surviving fraction (SF):

17. 通过将不同药物处理的结果(通常横坐标为不同浓度)进行排列,即可获得相应的结果。

图5. 肾癌细胞的克隆生长:亲代和耐药Caki-1的克隆生长(a), 786-O(b),KTCTL-26(c)和A-498(d)细胞用青蒿素琥酯(10-50μM)处理10天。未经处理的细胞作为对照(设置为100%)。误差线表示标准偏差(SD)。
参考文献:
[1] Cancers (Basel). 2020 Oct27;12(11):3150.
[2] Nat Protoc. 2006;1(5):2315-9.
-THE END-

更多代理产品请访问普洋仪器官网
http://www.gzpuyang.cn
联系我们
电话:020-38325399
邮箱:1036059367@qq.com
地址:广州市番禺区奥园城市天地
8-2-334室

